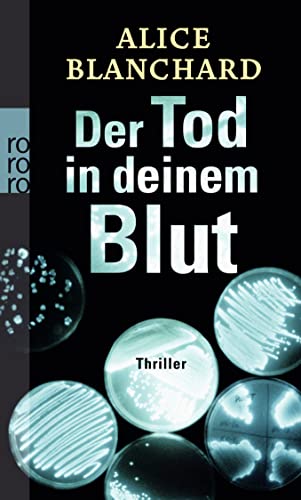

Betrachtet man das Cover von Alice Blanchards Thriller „Der Tod in deinem Blut“, keimt unweigerlich der Verdacht auf, es handle sich bei dem Buch um einen weiteren Medizinthriller, der außer schwierigen Begriffen nicht viel Neues enthält. Doch so kann man sich täuschen: Die Autorin schafft den Spagat zwischen einer medizinischen Rahmenhandlung und handfester Spannungslektüre.
Daisy Hubbard kann nicht unbedingt auf eine glückliche Kindheit zurückblicken. Der Vater ist früh gestorben, das Geld war knapp, der Stiefvater hat sie und ihre jüngere Schwester Anna sexuell missbraucht. Zudem ist ihr kleiner Bruder Louis noch im Kleinkindalter an der rezessiv vererbbaren, stets tödlich verlaufenden Krankheit Stier-Zellar gestorben. All diese Ereignisse haben dazu geführt, dass sie heute eine aufstrebende, ehrgeizige Wissenschaftlerin ist, die ein Heilmittel gegen Stier-Zellar finden möchte. Sie ist auf dem richtigen Weg: Ihre Gentherapie bringt in Tierversuchen gute Ergebnisse und sie arbeitet Tag und Nacht daran. Ihr Privatleben geht dabei verloren; auch zu ihrer Familie hat sie nur wenig Kontakt.
Das ändert sich, als ihre Mutter sie eines Tages anruft und ihr beunruhigt mitteilt, dass Anna verschwunden ist. Das ist an und für sich nichts Neues: Anna, die an Schizophrenie leidet, haut gerne mal ab, doch so lange war sie noch nie verschwunden. Ihr letztes Lebenszeichen kam aus L.A., und so macht Daisy sich auf den Weg in die Stadt der Schönen und Reichen. Die Polizei ermittelt bereits in diesem Fall, und wenig später nimmt sie – dank Daisys tatkräftiger Hilfe – Roy Gaines fest.
In seinem Kleiderschrank findet sich die Leiche eines anderen Vermissten, doch als man ihn nach Anna fragt, möchte er die Polizei nur in Daisys Beisein zum Grab ihrer Schwester führen. Doch an der Stelle im Wald, wo er die Polizisten hinführt, ist nicht Anna vergraben, sondern eine andere Tote. Daisys Nerven sind zum Zerreißen gespannt. Sie möchte endlich wissen, ob Anna noch lebt oder nicht. Roy Gaines nutzt ihren labilen Zustand aus, um sein Spielchen mit ihr und Ermittler Jack zu spielen. Ein Spiel, das Unerwartetes zutage befördert und sowohl für Daisy als auch für Jack tödlich enden kann …
Was anfangs wirklich wie ein trockener Laborthriller anmutet, entwickelt sich zu einer rasanten Suche nach Anna – ob tot oder lebendig. Alice Blanchard konstruiert eine spannende Handlung, die sehr elegant in die medizinische Rahmenhandlung eingebettet ist und als Zielgruppe weder angehende Medizinstudenten noch Frauenromanfans anspricht. Obwohl eine weibliche Hauptperson im Mittelpunkt steht, rutscht die Geschichte nie ins Melodramatische ab, sondern bleibt auf einem gleichmäßig hohen literarischen Level. Die Story ist kaum vorhersehbar und hält viele Überraschungen bereit. Sie weist keine Längen auf, denn selbst wenn einmal nichts passiert, ahnt der Leser, dass dies nur die Ruhe vor dem Sturm ist. „Der Tod in deinem Blut“ ist vom Anfang bis zum Ende spannend, alleine schon deshalb, weil man diese Handlung aufgrund der Buchaufmachung nicht erwartet.
Die Figuren der Geschichte sind unglaublich anschaulich und lebensgetreu gezeichnet. Mithilfe kleiner Details wie Kindheitserinnerungen oder Eigenheiten erschafft Alice Blanchard ein Personenensemble, das sowohl emotionalen Zündstoff als auch Identifikationsmöglichkeit für den Leser bietet. Jeder Charakter besitzt Stärken und Schwächen, negative und positive Seiten und der Autorin gelingt es, diese ins richtige Verhältnis zu setzen, so dass man sogar den bösen Charakteren am Ende vielleicht nichts Wohlwollendes abgewinnen kann, aber sie zumindest versteht. Das ist insofern keine einfache Aufgabe, als gerade Anna und Roy aufgrund ihres psychischen Zustandes alles andere als leicht zu verstehen sind. Doch Blanchard schafft es, auch diesen Charakteren Leben einzuhauchen und sie nie einseitig darzustellen.
Auf den ersten Blick wirkt der Schreibstil der Autorin sehr gewöhnlich, doch spätestens nach ein paar Seiten sollte man bemerkt haben, dass sie ein Händchen für kurze, aber prägnante Beschreibungen hat. Sie schafft es, mit wenigen Worten ein genaues Bild vor dem inneren Auge des Lesers heraufzubeschwören. Immer wieder setzt sie Akzente durch genaues Wissen und gute Recherche, ohne prahlerisch zu wirken.
„Der Tod in deinem Blut“ ist sicherlich nicht genresprengend, doch aufgrund der hohen Qualität von Handlung und Schreibstil auf jeden Fall überdurchschnittlich. Wirklich neu ist die Geschichte nicht, aber die Autorin baut sie ansehnlich und spannend auf, ohne dass sie sich allzu leicht vorhersehen lässt.
http://www.rowohlt.de